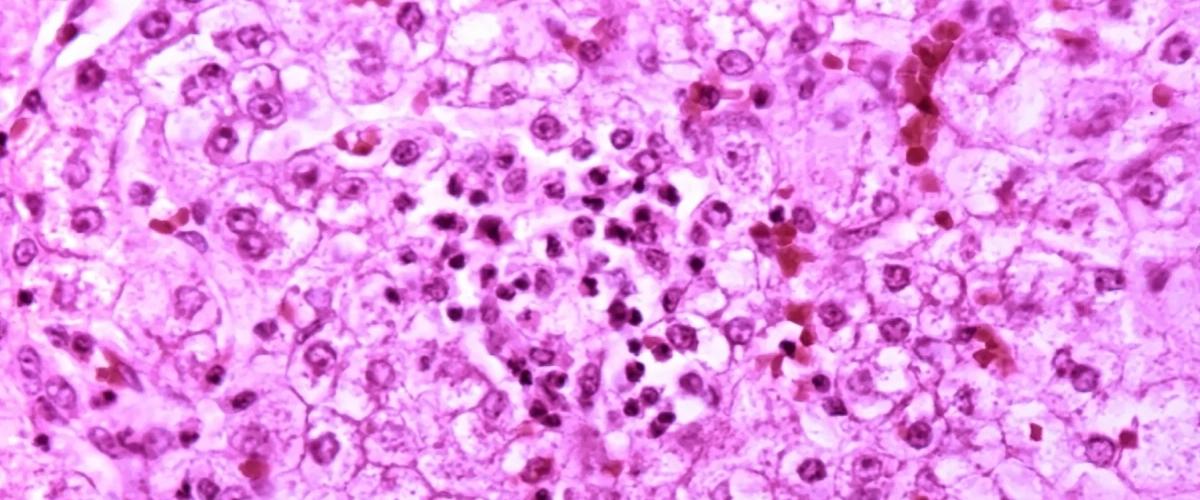
TODO:

Ученые из Университета Индианы обнаружили в цикле мочевины — ключевом процессе преобразования аммиака в организме — причину развития жировой болезни печени. По статистике, этот диагноз считается наиболее распространенным заболеванием печени у взрослых и детей. У пациентов в течение многих лет может происходить избыточное накопление жира в ткани печени, после чего хроническое воспаление приводит к развитию фиброза, а на последних стадиях развивается цирроз и рак печени.
Теперь ученые установили, что нарушения в цикле мочевины приводят к поломкам в цикле трикарбоновых кислот — ключевом сигнальному пути энергического обмена. В результате эти процессы способствуют неэффективному использованию калорий, избыточному накоплению жира и, в конечном итоге, воспалению и фиброзу.
«Ожирение печени связано с серьезными проблемами со здоровьем, поэтому теперь открытие обещает прорыв в профилактике и лечении болезни», — заявила соавтор работы Инь Цао.
Например, ученые уже продемонстрировали, что введение двух ферментов для нацеливания на новые мишени значительно снижает симптомы повреждения печени у мышей. Дальнейшие исследования позволят оценить потенциал нового лечения для человека.
Ранее другие ученые показали, что в результате неправильного питания изменяется функция Т-клеток и именно это является триггером целого каскада событий, которые ведут к развитию и прогрессированию жировой болезни печени.